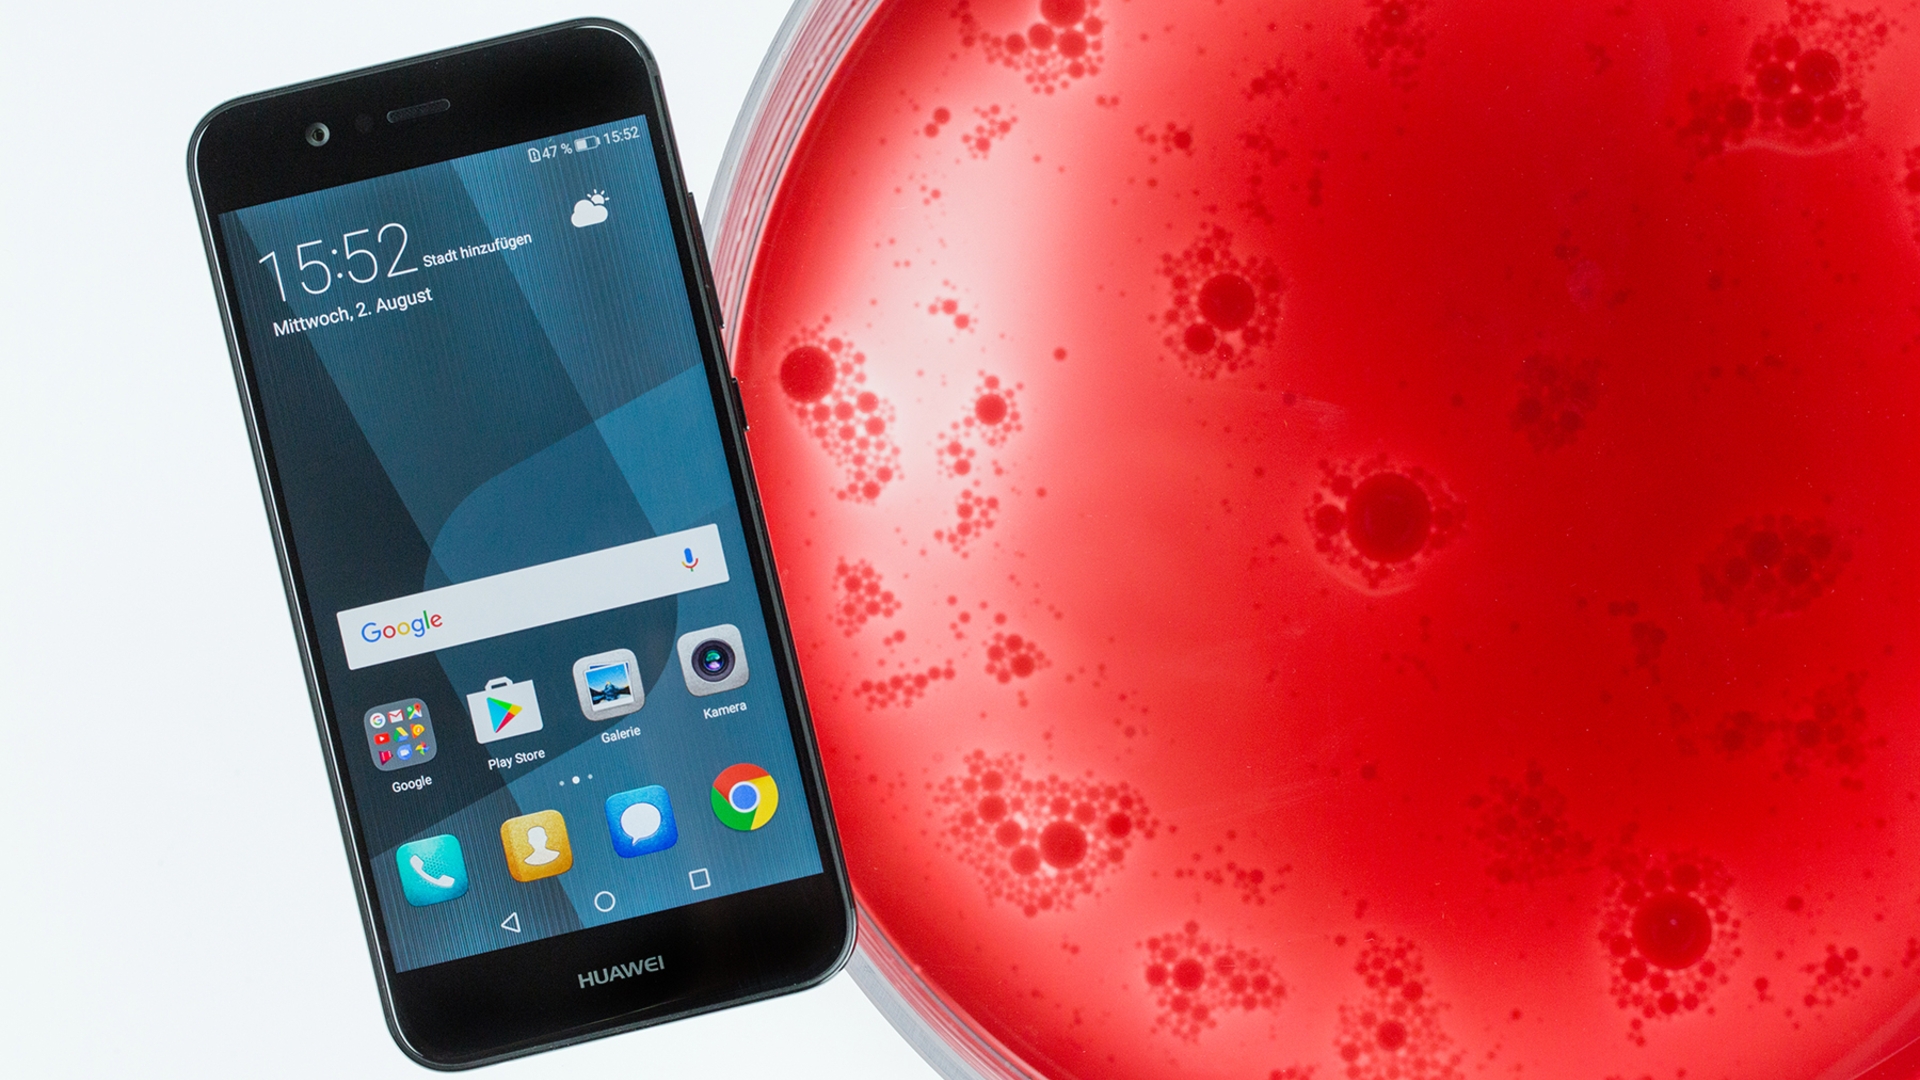

Mitte Juli 2018 wird das Design des Geräts erinnert, wie bereits berichtet, an das Huawei P20 Lite.
Huawei hat auf dem chinesischen Mikroblogging-Netzwerk Weibo ein Poster des Huawei Nova 3 veröffentlicht und damit bereits vor der eigentlichen Präsentation am 18. Juli 2018 einiges verraten: Auf dem Bild ist die komplette Vorderseite des Geräts zu sehen und weite Teile der Rückseite. Wir wissen nun auch, dass es das Smartphone mindestens in zwei Farbrichtungen (Hellblau und Gold) geben wird.
Doppelte Dualkamera
Eine Notch ziert das 6,3 Zoll große, fast randlose FHD-Plus-Display. Was allerdings nicht wirklich verwundert, da die Entwickler auf der Vorderseite zahlreiche Elemente unterbringen: Dort zu finden sind neben einer Ohrmuschel und weiteren Sensoren auch eine Dual-Selfiekamera (24 MP und 2 MP). Die Rückseite scheint aus Glas zu sein. Sie beheimatet ebenfalls eine Dualkamera (16 MP und 24 MP) sowie einen Fingerabdrucksensor.
Bereits vor einigen Tagen verriet die chinesische Regulierungsbehörde TENAA fast alle Details zum neuesten Mitglied der Nova-Serie. Demnach wird das Smartphone von einem Octa-Core-Prozessor angetrieben, bei dem es sich um den hauseigenen Kirin 659 oder Kirin 710 handeln soll, wie GSM Arena berichtet. Dem Chip stehen 6 GB Arbeitsspeicher und 64 GB beziehungsweise 128 GB interner Arbeitsspeicher zur Seite. Der Akku soll eine Kapazität von 3650 mAh haben.
#Huawei #Nova3 to Launch with Notch Display & Quad Cameras@tecksync#tecksync pic.twitter.com/F2Mxx3JZ9H
— tecksync (@tecksync) July 4, 2018
Auch interessant
Transparenz:Wir verwenden sog. Affiliate-Links. Kauft ihr etwas, erhalten wir ggf. eine Provision. Ihr zahlt dafür keinen Cent extra, unterstützt aber die Arbeit der CURVED-Redaktion.